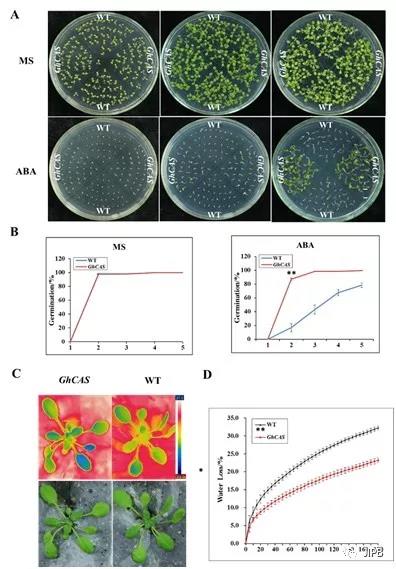

2019年8月8日JIPB在线发表河南大学棉花生物学国家重点实验室题为“Screening of abiotic stress-responsive cotton genes using a cotton full-length cDNA overexpressing Arabidopsis library”的研究论文(https://onlinelibrary.wiley.com/doi/10.1111/jipb.12861)。该研究利用FOX(Full-length cDNA over-eXpressing)Hunting System和高通量Gateway技术相结合构建出不同胁迫处理条件下棉花全长cDNA文库,创制了棉花-FOX-拟南芥超表达库,并通过多种胁迫条件快速高效地筛选到了156个参与胁迫响应的棉花基因。

图 1. 棉花-FOX-拟南芥超表达库的构建
棉花是世界上重要的经济作物和主要的天然纤维来源植物,具有重要的经济价值。在棉花生长发育过程中,常常会遭受各种非生物或生物胁迫,严重影响棉花产量和棉纤维品质。因此,研究棉花抗逆的遗传学和生物学机制,克隆抗逆关键基因并加以利用,培育抗逆棉花新品种,是当前棉花生产迫切需要解决的问题。
本研究对陆地棉(Gossypium hirsutum L.)栽培种中棉12进行干旱、盐、ABA、MeJA、SA等处理,利用FOX Hunting System和高通量Gateway技术相结合构建了棉花全长cDNA文库。为了快速高效地筛选棉花胁迫响应基因,通过转化模式植物拟南芥,创制了棉花-FOX-拟南芥超表达库,获得了6830个转基因拟南芥株系。对其中757个转基因拟南芥株系通过甘露醇、ABA、NaCl等胁迫条件的筛选,获得156个具有初步表型的转基因拟南芥,测序后获得了相应的棉花胁迫响应基因。进一步从156个基因中选取GhCAS、GhPOD、GhAPX、GhSDH四个基因,对其组织和逆境诱导表达模式进行分析,同时表型分析也进一步确认这四个基因参与植物的逆境胁迫响应。
图 2. 棉花GhCAS基因超表达拟南芥在ABA处理条件下的生长表型及叶温和失水率
棉花是木本植物,生育周期长,转化困难,而拟南芥的生育期只有6-8周,因此将棉花的基因导入拟南芥,以拟南芥为载体进行功能分析,可以大大加快研究进度。另外,棉花是异源四倍体作物,许多基因家族成员之间存在功能冗余。若直接在棉花植株体内研究这些基因的功能,因家族成员之间功能上的冗余,有时会掩盖被研究基因的真实效应。所以,本研究希望通过棉花-FOX-拟南芥库建立一种快速高效的棉花功能基因筛选体系,为棉花胁迫响应等功能基因的研究提供参考和帮助。
棉花生物学国家重点实验室的硕士研究生李胜婷和陈浩为论文的共同第一作者。宋纯鹏教授和王道杰教授为共同通讯作者。该项目得到国家重点研发计划和国家自然科学基金的支持。